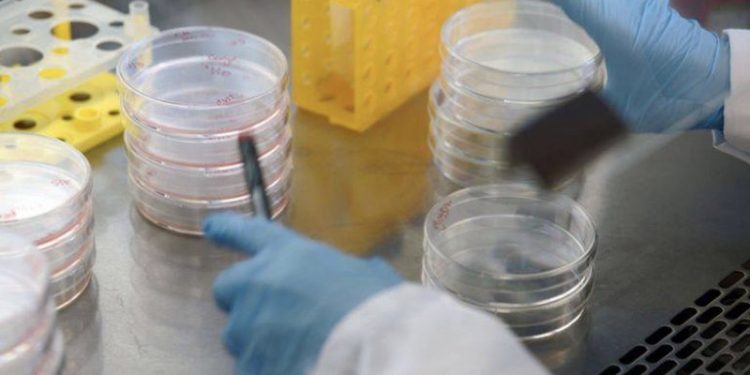

Një lajm i mirë vjen nga Kina ku thuhet se virusi në fund të marsit do të jetë shumë i dobët dhe mund te ketë rënie të mëdha të infektuarve.
Profesori Zhang Boli, një anëtar i ekipit të ekspertëve të caktuar nga Pekini thotë se muaji mars deri në prill do të jenë muajt e fundit të qarkullimit të virusit.
Prof Zhang është anëtar i Akademisë së Inxhinierisë Kineze si dhe President i Universitetit Tianjin të Mjekësisë Tradicionale Kineze. Ai i bëri komentet gjatë një interviste me People Daily ku dha një shprese të re.

Diskutime rreth kësaj post